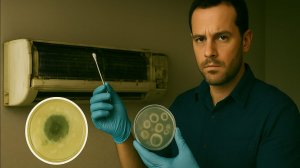
Плесень в Кондиционере: Взрыв Aspergillus за 24 Часа! Полный Эксперимент + Чистка СПб (60 мин) 😱

8:55
8:55
2025-05-31 00:17

 7:44
7:44

 7:44
7:44
2024-02-01 11:38

 12:55
12:55

 12:55
12:55
2025-11-21 13:42

 2:26
2:26

 2:26
2:26
2025-06-04 12:48

 42:36
42:36

 42:36
42:36
2025-09-18 20:01

 1:13
1:13

 1:13
1:13
2025-03-22 09:44

 58:33
58:33
58:33
58:33
2025-11-15 11:00

 14:38
14:38

 14:38
14:38
2024-01-26 13:02

 10:36
10:36

 10:36
10:36
2025-01-02 21:15

 57:20
57:20

 57:20
57:20
2025-09-21 10:30

 3:02:41
3:02:41

 3:02:41
3:02:41
2025-09-14 21:30

 7:08
7:08

 7:08
7:08
2022-03-07 09:19

 5:53
5:53

 5:53
5:53
2023-11-18 11:12

 11:42
11:42

 11:42
11:42
2023-08-10 16:10

 29:14
29:14

 29:14
29:14
2023-08-23 12:58

 1:52
1:52

 1:52
1:52
2023-11-17 23:25

 6:59
6:59

 6:59
6:59
2023-08-31 13:11

 9:14
9:14
![Инна Вальтер - Татарский взгляд (Премьера клипа 2025)]() 3:14
3:14
![Алмас Багратиони - Дети света (Премьера клипа 2025)]() 2:52
2:52
![Маша Шейх - Будь человеком (Премьера клипа 2025)]() 2:41
2:41
![Бекзод Хаккиев - Айтаман (Премьера клипа 2025)]() 2:41
2:41
![10AGE, Роса ft. С. Есенин - Вот уж вечер (Премьера клипа 2025)]() 4:01
4:01
![Владимир Ждамиров, Игорь Кибирев - Тик так (Премьера 2025)]() 3:30
3:30
![Карина Салагати - Сердце горца (Премьера клипа 2025)]() 3:18
3:18
![Tural Everest, Руслан Добрый - Красивая (Премьера клипа 2025)]() 3:16
3:16
![Эльдар Агачев - Путник (Премьера клипа 2025)]() 3:14
3:14
![Леся Кир - Альфонс (Премьера клипа 2025)]() 3:23
3:23
![Like Nastya – Fly Girl (Official Video 2025)]() 2:01
2:01
![Катя Маркеданец - Мама (Премьера клипа 2025)]() 3:32
3:32
![Рейсан Магомедкеримов - Моя мадам (Премьера клипа 2025)]() 3:28
3:28
![Джатдай - Тобою пленен (Премьера клипа 2025)]() 1:59
1:59
![Зульфия Чотчаева - Холодное сердце (Премьера клипа 2025)]() 2:52
2:52
![Ахрор Гуломов - Ёмгирлар (Премьера клипа 2025)]() 3:49
3:49
![Соня Белькевич - Подогналась (Премьера клипа 2025)]() 3:13
3:13
![Сергей Сухачёв - Я наизнанку жизнь (Премьера клипа 2025)]() 3:07
3:07
![Динара Швец - Нас не найти (Премьера клипа 2025)]() 3:46
3:46
![Вика Ветер - Еще поживем (Премьера клипа 2025)]() 4:31
4:31
![Плохой Санта 2 | Bad Santa 2 (2016) (Гоблин)]() 1:34:55
1:34:55
![Французский любовник | French Lover (2025)]() 2:02:20
2:02:20
![Мужчина у меня в подвале | The Man in My Basement (2025)]() 1:54:48
1:54:48
![Франкенштейн | Frankenstein (2025)]() 2:32:29
2:32:29
![Чёрный телефон 2 | Black Phone 2 (2025)]() 1:53:55
1:53:55
![Большое смелое красивое путешествие | A Big Bold Beautiful Journey (2025)]() 1:49:20
1:49:20
![Стив | Steve (2025)]() 1:33:34
1:33:34
![Кей-поп-охотницы на демонов | KPop Demon Hunters (2025)]() 1:39:41
1:39:41
![Гедда | Hedda (2025)]() 1:48:23
1:48:23
![Терминатор 2: Судный день | Terminator 2: Judgment Day (1991) (Гоблин)]() 2:36:13
2:36:13
![Все дьяволы здесь | All the Devils are Here (2025)]() 1:31:39
1:31:39
![Орудия | Weapons (2025)]() 2:08:34
2:08:34
![Диспетчер | Relay (2025)]() 1:51:56
1:51:56
![Безжалостная | Stone Cold Fox (2025)]() 1:25:31
1:25:31
![Только ты | All of You (2025)]() 1:38:22
1:38:22
![Тот самый | Him (2025)]() 1:36:20
1:36:20
![Битва за битвой | One Battle After Another (2025)]() 2:41:45
2:41:45
![Бешеные псы | Reservoir Dogs (1991) (Гоблин)]() 1:39:10
1:39:10
![Плохой Cанта 2 | Bad Santa 2 (2016) (Гоблин)]() 1:28:32
1:28:32
![Свайпнуть | Swiped (2025)]() 1:50:35
1:50:35
![Сандра - сказочный детектив Сезон 1]() 13:52
13:52
![Новогодние мультики – Союзмультфильм]() 7:04
7:04
![Простоквашино. Финансовая грамотность]() 3:27
3:27
![МегаМен: Полный заряд Сезон 1]() 10:42
10:42
![Котёнок Шмяк]() 11:04
11:04
![Папа Супергерой Сезон 1]() 4:28
4:28
![Артур и дети круглого стола]() 11:22
11:22
![Хвостатые песенки]() 7:00
7:00
![Енотки]() 7:04
7:04
![Тёплая анимация | Новая авторская анимация Союзмультфильма]() 10:46
10:46
![Пиратская школа]() 11:06
11:06
![Полли Покет Сезон 1]() 21:30
21:30
![Роботы-пожарные]() 12:31
12:31
![Зомби Дамб]() 5:14
5:14
![Ну, погоди! Каникулы]() 7:09
7:09
![Пингвиненок Пороро]() 7:42
7:42
![Новое ПРОСТОКВАШИНО]() 6:30
6:30
![Тодли Великолепный!]() 3:15
3:15
![Агент 203]() 21:08
21:08
![МиниФорс]() 0:00
0:00

 9:14
9:14Скачать Видео с Рутуба / RuTube
| 256x144 | ||
| 640x360 | ||
| 1280x720 | ||
| 1920x1080 |
 3:14
3:14
2025-11-18 11:36
 2:52
2:52
2025-11-20 13:43
 2:41
2:41
2025-11-12 12:48
 2:41
2:41
2025-11-17 14:22
 4:01
4:01
2025-11-11 17:26
 3:30
3:30
2025-11-13 11:12
 3:18
3:18
2025-11-19 11:48
 3:16
3:16
2025-11-12 12:12
 3:14
3:14
2025-11-12 12:52
 3:23
3:23
2025-11-19 11:51
 2:01
2:01
2025-11-10 13:14
 3:32
3:32
2025-11-17 14:20
 3:28
3:28
2025-11-20 13:54
 1:59
1:59
2025-11-15 12:25
 2:52
2:52
2025-11-18 11:48
 3:49
3:49
2025-11-15 12:54
 3:13
3:13
2025-11-14 11:41
 3:07
3:07
2025-11-14 13:22
 3:46
3:46
2025-11-12 12:20
 4:31
4:31
2025-11-11 12:26
0/0
 1:34:55
1:34:55
2025-09-23 22:53
 2:02:20
2:02:20
2025-10-01 12:06
 1:54:48
1:54:48
2025-10-01 15:17
 2:32:29
2:32:29
2025-11-17 11:22
 1:53:55
1:53:55
2025-11-05 19:47
 1:49:20
1:49:20
2025-10-21 22:50
 1:33:34
1:33:34
2025-10-08 12:27
 1:39:41
1:39:41
2025-10-29 16:30
 1:48:23
1:48:23
2025-11-05 19:47
 2:36:13
2:36:13
2025-10-07 09:27
 1:31:39
1:31:39
2025-10-02 20:46
 2:08:34
2:08:34
2025-09-24 22:05
 1:51:56
1:51:56
2025-09-24 11:35
 1:25:31
1:25:31
2025-11-10 21:11
 1:38:22
1:38:22
2025-10-01 12:16
 1:36:20
1:36:20
2025-10-09 20:02
 2:41:45
2:41:45
2025-11-14 13:17
 1:39:10
1:39:10
2025-09-23 22:53
 1:28:32
1:28:32
2025-10-07 09:27
 1:50:35
1:50:35
2025-09-24 10:48
0/0
2021-09-22 20:39
 7:04
7:04
2023-07-25 00:09
 3:27
3:27
2024-12-07 11:00
2021-09-22 21:43
 11:04
11:04
2023-05-18 16:41
2021-09-22 21:52
 11:22
11:22
2023-05-11 14:51
 7:00
7:00
2025-06-01 11:15
 7:04
7:04
2022-03-29 18:22
 10:46
10:46
2022-06-07 11:02
 11:06
11:06
2022-04-01 15:56
2021-09-22 23:09
2021-09-23 00:12
 5:14
5:14
2024-11-28 13:12
 7:09
7:09
2025-08-19 17:20
 7:42
7:42
2024-12-17 12:21
 6:30
6:30
2018-04-03 10:35
 3:15
3:15
2025-06-10 13:56
 21:08
21:08
2025-01-09 16:39
 0:00
0:00
2025-11-21 15:26
0/0

